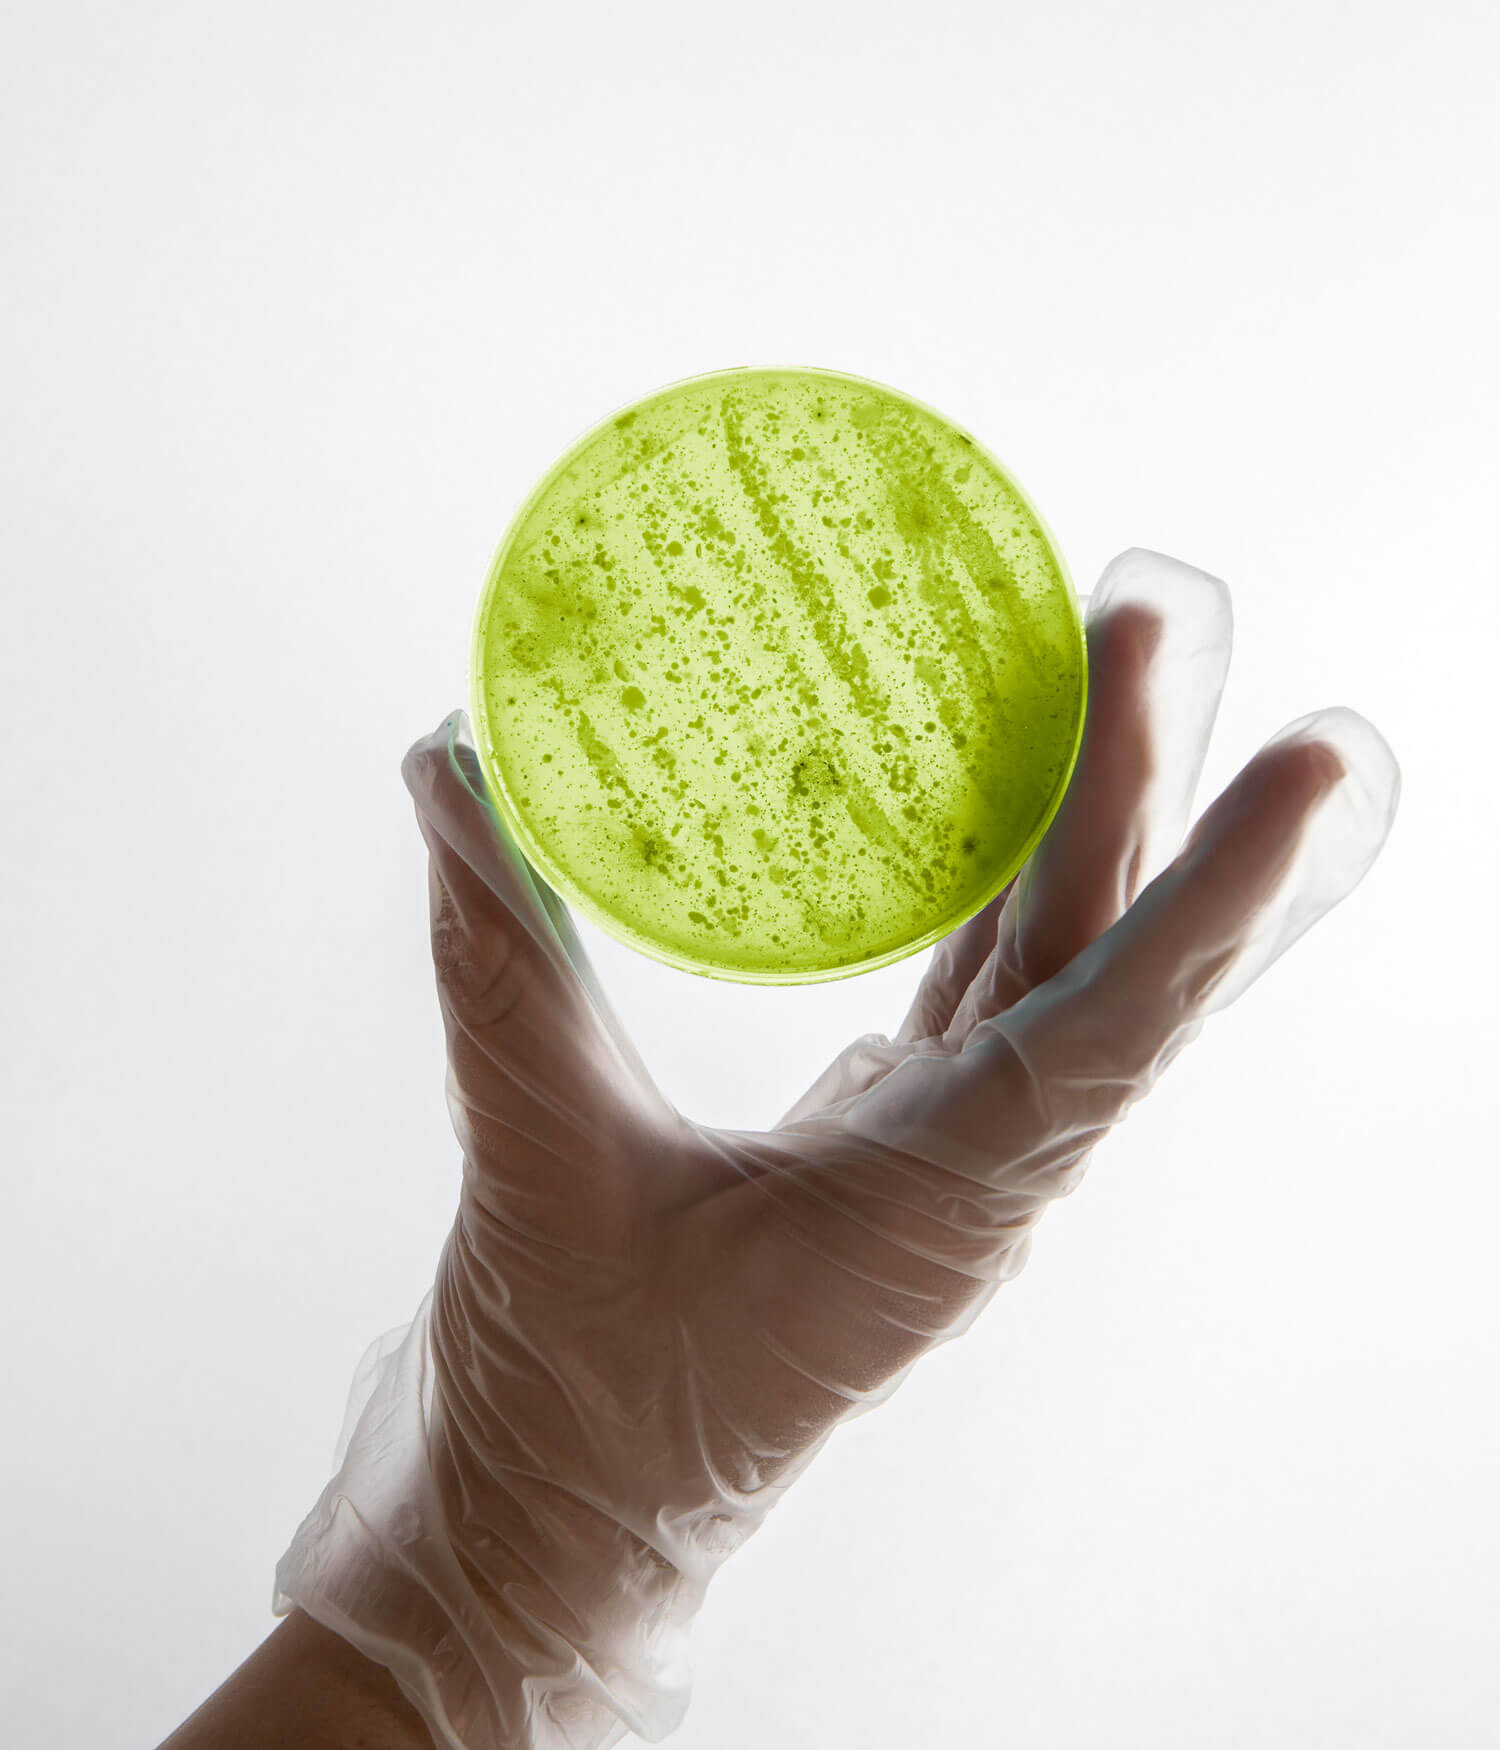

Exir Simiya |
Chemical Group
Corporate Design
Logo Design
Verpackung Design
2024

Die Exir Simiya Chemical Group ist in Iran als Hersteller von chemischen Produkten für Landwirtschaft und Anbau tätig. Als neues Unternehmen setzt es auf modernste Technologien, um seine Produkte erfolgreich auf den internationalen Märkten zu etablieren.
Die Logo-Gestaltung für dieses Unternehmen stellte eine Herausforderung dar: Es galt, ein Symbol zu schaffen, das die essentielle Philosophie der Gruppe verkörpert, basierend auf den Prinzipien der chemischen Wissenschaften, Labortechnologie und Technik.
Das abschließende Logo wurde konzipiert, indem es geschickt den Anfangsbuchstaben des Firmennamens mit einer Darstellung molekularer Verknüpfungen verschmilzt, die in einem Laborumfeld entstehen. Durch die geschickte Verbindung von visuellen Elementen wird die Brücke zwischen der Identität des Unternehmens und den grundlegenden wissenschaftlichen Prinzipien geschlagen, die in den Laboren der chemischen Industrie eine Rolle spielen. Diese gestalterische Verbindung erfasst nicht nur die technische Raffinesse des Unternehmens, sondern verankert auch seine Philosophie und Innovationskraft in einem visuell fesselnden Logo-Konzept.

Eines der innovativen Produkte dieses Unternehmens ist TERA PELEX. Bei der Gestaltung der Verpackung dieses Produkts wurden Aspekte wie strukturelle und farbliche Unterscheidungsmerkmale im Vergleich zu Konkurrenzprodukten berücksichtigt. Dabei wurden die Branding-Elemente des Herstellers in modernen und passenden Formen und Farben betont, um sicherzustellen, dass das äußere Erscheinungsbild des Produkts vollständig zur Qualität des Produkts spricht und gleichzeitig das Branding des Unternehmens widerspiegelt.



Außerdem werden die anderen Produkte dieses Unternehmens, wie bereits erwähnt, mithilfe modernster Wissenschaften und Technologien hergestellt und auf den Agrarmarkt gebracht. Daher sollte auch das Design der Etiketten und Verpackungen dieser Produkte die Qualität hervorheben und im Wettbewerb mit anderen Produkten und Unternehmen das Branding des Herstellers vermitteln sowie einen Einblick in deren Innovationscharakter geben.
Aktuell produziert und vertreibt dieses Unternehmen drei Arten von Produkten in flüssiger Form als Pestizide. Auch das Design und die Farbauswahl dieser Produkte wurden entsprechend ihrer Funktion und passend zur Markenidentität berücksichtigt.

Das Packaging-Design jedes dieser Produkte wurde individuell konzipiert und umgesetzt, basierend auf ihrem jeweiligen Einsatzzweck und der Art des Verbrauchs. Die Aufrechterhaltung der Produktwahrnehmung in den Köpfen der Verbraucher stellte eine anspruchsvolle Herausforderung dieses Projekts dar. Dabei wurden geometrische Formen und sorgfältig ausgewählte, ausdrucksstarke Farbpaletten berücksichtigt, um eine dauerhafte visuelle Präsenz zu schaffen. Diese gestalterischen Entscheidungen wurden nicht nur getroffen, um die Qualität zu betonen, sondern auch, um das Markenimage auf eine kohärente und ansprechende Art und Weise widerzuspiegeln.







